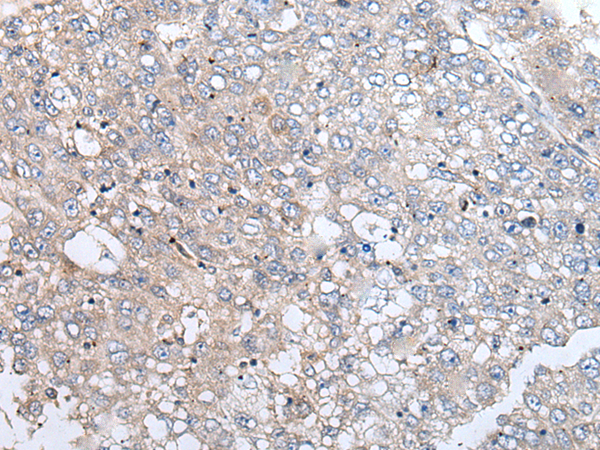

中文名稱: 兔抗URGCP多克隆抗體
|
Background: |
URG4 is upregulated in the presence of hepatitis B virus (HBV)-encoded X antigen (HBxAg) and may contribute to the development of hepatocellular carcinoma by promoting hepatocellular growth and survival (Tufan et al., 2002 [PubMed 12082552]). |
|
Applications: |
ELISA, IHC |
|
Name of antibody: |
URGCP |
|
Immunogen: |
Synthetic peptide of human URGCP |
|
Full name: |
upregulator of cell proliferation |
|
Synonyms: |
URG4 |
|
SwissProt: |
Q8TCY9 |
|
ELISA Recommended dilution: |
500-1000 |
|
IHC positive control: |
Human liver cancer |
|
IHC Recommend dilution: |
20-100 |
購物車
購物車 幫助
幫助
 021-54845833/15800441009
021-54845833/15800441009
